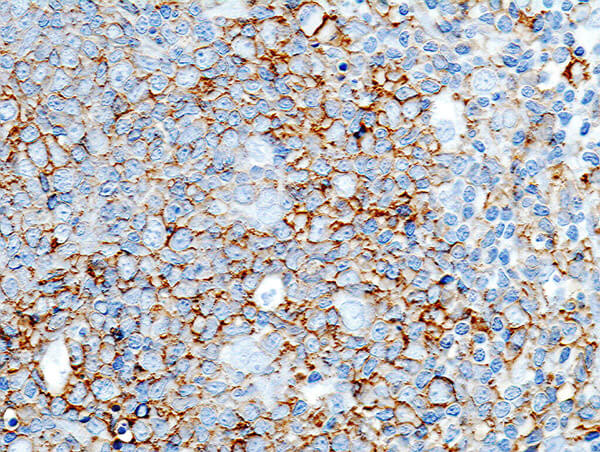
Image of Diffuse large B cell lymphoma for CD20.

Creative Biolabs is one of the leading custom antibody generation and development providers. We specialize in the generation of antibodies against a wide range of targets for R&D, diagnostic, and therapeutic applications. Currently, we have launched a series of in vitro diagnostic (IVD) antibody development services targeting numerous diagnostic biomarkers of human diseases. Here, we focus on the CD20 as a marker of lymph cancer.
B-Lymphocyte Antigen CD20
B-lymphocyte antigen CD20 or CD20 is encoded by the MS4A1 gene in humans. It is an activated-glycosylated phosphoprotein expressed on the surface of all B-cells beginning at the pro-B phase (CD45R+, CD117+) and progressively increasing in concentration until maturity. CD20 has no known natural ligand. The function of the protein is to achieve the best B cell immune response, especially against T-independent antigens. It is suspected that it acts as a calcium channel in the cell membrane. CD20 has been shown to play a role in the microenvironment interactions of B cells.
Fig.1 Diffuse large B cell lymphoma for CD20. Distributed under CC BY-SA 3.0, from Wiki, without modification.
Fig.1 Diffuse large B cell lymphoma for CD20. Distributed under CC BY-SA 3.0, from Wiki, without modification.
CD20 Marker of Lymph Cancer
Mature T-cell lymphomas are relatively rare, accounting for approximately 10% of non-Hodgkin's lymphomas worldwide. Hematopoietic tumors of this type are clinically aggressive and show poor response to treatment, and shortened survival. They are more common in Native American descendants or Asian. The differentiation of B-cell and T-cell lymphomas is critical because T-cell lymphomas are more aggressive with a much poorer response and should be treated with different chemotherapeutic agents.
Historically, CD20 has been regarded as a specific B-cell marker. It has long been thought to be a specific marker for B-cell lineage and has been used to help differentiate T-cell and B-cell neoplasms. Many of the individual B-cell neoplasms show characteristic morphologic features and the majority of B-cell lymphomas show reproducible profiles of CD marker expression, particularly CD20. This marker has been thought to be specific for B-cells, both benign and malignant.
IVD Antibody Development Service Targeting CD20 Marker
IVD antibodies are extensively used in immunodiagnostic tools for disease screening and therapeutic monitoring. Through our role as a leading antibody service provider, Creative Biolabs is well-positioned to develop high-quality CD20-specific antibodies. Besides antibody generation, Creative Biolabs also offers diagnostic immunoassay development services, including feasibility analysis, assay design, assay protocol establishment, assay optimization, and kit production.
Creative Biolabs has successfully completed a number of IVD antibody generation and development projects for clients across the globe. If you are interested in our IVD antibody discovery services, please contact us for more details.
For Research Use Only.